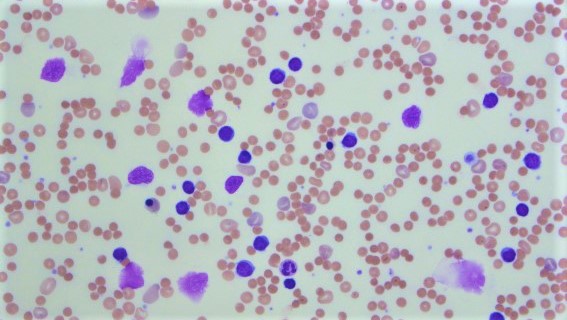
慢性リンパ性白血病 (CLL) の症状症状

Reblozyl は、特定の血液疾患を持つ成人の貧血のために処方されるブランド注射剤です。 Reblozyl には有効成分 luspatercept-aamt が含まれています。
食品医薬品局 (FDA) は、特定の血液疾患を持つ成人の貧血(赤血球数の減少) を治療するために Reblozyl を承認しました。具体的には、次のような成人に使用されます。
- ベータサラセミア、赤血球がヘモグロビンを正しく生成しない遺伝性疾患
- 特定のタイプの骨髄異形成症候群 (MDS) 、骨髄および血液細胞に影響を与える癌のグループ
これらの用途では、これらの症状のある人は定期的な赤血球輸血が必要であるか、必要になる可能性があります。 Reblozyl の承認された使用法の詳細については、「 Reblozyl の使用」セクションを参照してください。
注: Reblozyl は、貧血をすぐに改善する必要がある人々の赤血球輸血の代わりには使用されていません。
薬剤の詳細
Reblozyl に関する重要な情報は次のとおりです。
- 薬剤クラス:赤血球成熟剤
- 剤形:皮下注射剤
- ジェネリックまたはバイオシミラーは利用可能ですか?いいえ
- 処方箋は必要ですか?はい
- 規制物質?いいえ
- FDA の承認年:
- ベータサラセミアによる貧血: 2019
- 特定の種類の MDS によって引き起こされる貧血: 2020

レブロジルは、ブランド医薬品としてのみ入手可能な生物学的医薬品です。生物学的製剤とは、生きた細胞を使って作られる薬です。 Reblozyl は現在、ジェネリックまたはバイオシミラーの形で入手できません。
ジェネリック医薬品は、ブランド医薬品に含まれる有効医薬品の正確なコピーです。バイオシミラー医薬品は、ブランド名の生物学的医薬品の有効成分と類似した医薬品です。 (生物学的製剤の正確なコピーを作成することは不可能です。)
ジェネリック医薬品とバイオシミラーは、その元になっているブランド薬と同様に安全で有効であると考えられています。通常、ブランド薬よりも安価です。

食品医薬品局 (FDA) は、特定の症状を治療するために Reblozyl などの処方薬を承認しています。レブロジルは、他の症状に対して適応外で使用することもできます。適応外医薬品の使用とは、FDA が承認した目的以外の目的で医薬品を使用することを意味します。
ベータサラセミアによる貧血に対するレブロジル
Reblozyl は、定期的な赤血球輸血を必要とするベータサラセミアの成人の貧血(赤血球数の減少)を治療するために FDA に承認されています。
ベータサラセミアと貧血について
ベータサラセミアは遺伝性の血液疾患です(遺伝子を通じて受け継がれます)。ベータサラセミアでは、突然変異と呼ばれる特定の遺伝子変化により、赤血球がヘモグロビンを正しく生成できなくなります。 (ヘモグロビンは、体の周りに酸素を移動させる赤血球内の分子です。)
その結果、体内で生成されるヘモグロビンが減少します。これは、未熟な赤血球が成熟した赤血球になるのを阻止する特定の信号を引き起こします。
未熟な赤血球が骨髄内に蓄積すると、健康な赤血球が発生して成熟するためのスペースが少なくなります。このため、ベータサラセミア患者の血液中の赤血球とヘモグロビンのレベルが低くなります。
貧血は次のような症状を引き起こす可能性があります。
ベータサラセミアのある人は、軽度または重度の貧血を患っている可能性があります。これは、両親の一方または両方から特定の遺伝子変異を受け継ぐかどうかによって異なります。
定期的に赤血球を輸血すると、血液中にさらに多くの赤血球が追加されます。赤血球のレベルを増加させ、貧血を治療します。ただし、赤血球には鉄が豊富に含まれているため、肝臓、心臓、脾臓などの臓器に鉄が蓄積する可能性もあります。その後、過剰な鉄を除去するためにキレート剤と呼ばれる処理が必要になります。
ベータサラセミアによる貧血に対するレブロジルについて
レブロジルは赤血球のレベルを増加させます。これにより、健康な赤血球が骨髄内で成熟することが可能になります。これにより、鉄レベルを増加させることなく貧血が治療されます。
注: Reblozyl は、貧血をすぐに改善する必要がある人に対する赤血球輸血の代わりに使用されません。
βサラセミアによる貧血への効果
臨床試験では、定期的な赤血球輸血が必要なベータサラセミアの成人の貧血に対して、レブロジルが効果的な治療法であることが判明しました。この薬は、この症状を持つ人々に必要な赤血球輸血の回数を減らすことが示されています。
Reblozyl が臨床試験でどのような成績を収めたかを知るには、薬剤の処方情報を参照してください。
骨髄異形成症候群による貧血に対するレブロジル
Reblozyl は、特定のタイプの骨髄異形成症候群 (MDS)を患う成人の貧血 (赤血球数の減少) を治療するために FDA からも承認されています。
MDSと貧血について
MDS は、骨髄および血液細胞に影響を与えるがんのグループです。血液細胞は通常、骨髄(骨の内部の海綿状組織)内の幹細胞から発生します。しかし、MDS では幹細胞が異常になり、成熟した血液細胞に成長しなくなります。代わりに、それらは芽球と呼ばれる未熟な血球に成長します。
これにより、1 つ以上の種類の血球、特に赤血球のレベルが低下します。これが貧血の原因となります。 (貧血症状のリストについては、前セクションの「ベータサラセミアによる貧血に対するレブロジル」を参照してください。)
MDSによる貧血に対するレブロジルについて
レブロジルは、貧血の治療に赤血球生成刺激剤(ESA)と呼ばれる薬剤を使用していないMDS患者の貧血を治療するためにFDAから承認されています。 (これは ESA ナイーブと呼ばれます。)この MDS を持つ人々は、定期的な赤血球輸血が必要な場合があります。
Reblozylは、貧血に効果がなかったESAを使用し、8週間にわたって2つ以上の赤血球ユニットを必要とした人々のMDSによって引き起こされる貧血の治療にも承認されています。また、定期的な赤血球輸血も必要です。この場合、Reblozyl は以下の治療に承認されています。
- リング鉄芽球を含む MDS (MDS-RS)。リング鉄芽細胞は、過剰な鉄を含む未熟な赤血球です。
- 環状鉄芽細胞および血小板増加症を伴う骨髄異形成/骨髄増殖性新生物 (MDS/MPN-RS-T)。血小板増加症では、体内の血小板が過剰になります。
前述の基準に加えて、MDS は白血病に発症するリスクが非常に低いか中程度である必要があります。 MDS 患者のほとんどは、このように状態が進行するリスクは低いです。医師がデータシートのリスクレベルを決定します。
レブロジルは赤血球のレベルを増加させます。その後、より多くの健康な赤血球が骨髄内で成熟できるようになります。これにより、赤血球輸血によって鉄分濃度が上昇することなく、貧血が治療されます。
注: Reblozyl は、貧血をすぐに改善する必要がある人に対する赤血球輸血の代わりに使用されません。
MDSによる貧血に対する効果
レブロジルは、今述べたタイプの MDS を患う成人の貧血の効果的な治療法です。この薬は、MDS 患者における赤血球輸血の必要性を減らすのに役立つことが示されています。 Reblozyl が臨床試験でどのような成績を収めたかを知るには、薬剤の処方情報を参照してください。
National Comprehensive Cancer Network のガイドラインには、特定の種類の MDS によって引き起こされる貧血の治療選択肢として Reblozyl が含まれています。
レブロジルと子供たち
レブロジルは小児への使用は承認されていません。レブロジルが子供にとって安全か有効かどうかは不明です。
MDS またはベータサラセミアの子供がいる場合は、治療の選択肢について医師に相談してください。

すべての薬と同様に、Reblozyl の価格は変動する可能性があります。実際に支払う価格は、保険プラン、所在地、利用する薬局によって異なります。
Reblozyl を注文できるのは医師または医療専門家だけであることに注意することが重要です。この薬は、医師の診察室、点滴クリニック、または同様の医療施設などの場所でのみ投与されます。レブロジルを薬局で受け取ることはできません。
Reblozyl の補償を承認する前に、保険会社が事前の承認を得るように要求する場合があります。これは、保険会社が薬を補償する前に、医師と保険会社が処方箋について連絡する必要があることを意味します。保険会社は事前の承認申請を検討し、その医薬品を補償するかどうかを決定します。
Reblozyl の事前承認が必要かどうか不明な場合は、保険会社にお問い合わせください。
財政および保険の援助
Reblozyl の費用を支払うために経済的サポートが必要な場合、または保険の補償範囲について理解するためのサポートが必要な場合は、サポートが利用できます。
Reblozyl の製造元は、Reblozyl のコスト削減に役立つ BMS Access Support と呼ばれるプログラムを提供しています。詳細およびサポートを受ける資格があるかどうかを確認するには、800-861-0048 に電話するか、製造元の Web サイトにアクセスしてください。
処方薬の節約について詳しくは、こちらをご覧ください。
ジェネリック版またはバイオシミラー版
Reblozyl はジェネリックまたはバイオシミラーの形では入手できません。
ジェネリック医薬品は、ブランド医薬品に含まれる有効医薬品の正確なコピーです。バイオシミラー医薬品は、ブランド名の生物学的医薬品の有効成分と類似した医薬品です。生物製剤は生きた細胞を使って作られます。生物学的製剤の正確なコピーを作成することは不可能です。
ジェネリック医薬品とバイオシミラーは、その元になっているブランド薬と同様に安全で有効であると考えられています。ブランド医薬品に比べて価格が安い傾向があります。
医師が処方するレブロジルの投与量は、いくつかの要因によって異なります。これらには次のものが含まれます。
- 体重(キログラム)
- 血液中のヘモグロビンのレベル
- 必要な赤血球輸血の数
医師は、あなたに適した量になるよう、時間の経過とともに投与量を調整する場合があります。最終的には、望ましい効果が得られる最小の用量を処方します。
以下の情報は、一般的に使用または推奨される投与量について説明しています。ただし、医師はあなたのニーズに合わせて最適な投与量を決定します。
薬の形と強さ
レブロジルは皮下注射によって投与されます。医療専門家がオフィスまたは診療所で注射を行います。
Reblozyl は、単回用量のバイアルに入った粉末として提供されます。 25 ミリグラム (mg) と 75 mg の 2 つの強度で入手できます。医療専門家は粉末を滅菌水と混合し、正しい用量を測定して注射します。
ベータサラセミアまたは骨髄異形成症候群による貧血の場合の投与量
ベータサラセミアまたは骨髄異形成症候群(MDS)による貧血の成人の通常の開始用量は、体重1kgあたり1mg(mg/kg)です。通常、これは3週間に1回投与されます。
医師は毎回の投与前にヘモグロビンレベルをチェックし、必要に応じて投与量を調整します。 Reblozyl は、必要な赤血球輸血の数を減らすことを目的としています。リブロジルを開始用量で 2 回注射しても必要な赤血球輸血の数が減らない場合、医師は用量を増やすことがあります。診察のたびにあなたに適した投与量を決定します。
ベータサラセミアによって引き起こされる貧血の最大用量は 1.25 mg/kg で、3 週間に 1 回投与されます。
MDS によって引き起こされる貧血に対する最大用量は 1.75 mg/kg で、3 週間に 1 回投与されます。
Reblozyl を最大用量で 3 回注射しても必要な赤血球輸血の数が減らない場合は、この薬が効かない可能性があります。この場合、Reblozyl の使用を中止する必要があります。医師は貧血の管理に役立つ代替治療法を推奨することがあります。
飲み忘れた場合はどうなりますか?
レブロジルの投与予約を忘れた場合は、すぐに医師の診察室に電話して予約を変更してください。飲み忘れた分はできるだけ早く服用してください。 3 週間後に次の投与を受けます。次の投与は少なくとも 3 週間の間隔をあけてください。
レブロジル投与の予約を逃さないようにするには、携帯電話にリマインダーを設定してみてください。
この薬は長期間使用する必要がありますか?
レブロジルは長期治療として使用することを目的としています。あなたと医師がレブロジルが安全で効果的であると判断した場合、おそらく長期にわたって服用することになります。

レブロジルは軽度または重篤な副作用を引き起こす可能性があります。以下のリストには、Reblozyl の投与中に発生する可能性のある主な副作用のいくつかが含まれています。これらのリストには、考えられるすべての副作用が含まれているわけではありません。
Reblozyl の副作用の可能性について詳しくは、医師または薬剤師に相談してください。あなたを心配したり悩ませたりする可能性のある副作用に対処する方法についてのヒントを与えることができます。
注:食品医薬品局 (FDA) は、承認した医薬品の副作用を追跡しています。 Reblozyl で生じた副作用について FDA に通知したい場合は、MedWatch を通じて行うことができます。
軽度の副作用
Reblozyl の軽度の副作用には次のようなものがあります。
- 倦怠感
- 頭痛
- 筋肉、骨、関節の痛み
- めまいまたは回転する感覚
- 下痢
- 吐き気
- 咳
- 腹痛
- 息切れ
- 風邪などの上気道感染症
これは、Reblozyl による軽度の副作用の部分的なリストです。その他の軽度の副作用について知りたい場合は、医師または薬剤師に相談するか、Reblozyl の処方情報をご覧ください。
これらの副作用のほとんどは、数日または数週間以内に消える可能性があります。ただし、症状が悪化したり、治らない場合は、医師または薬剤師に相談してください。
重篤な副作用
Reblozyl による重篤な副作用は一般的ではありませんが、発生する可能性があります。重篤な副作用がある場合は、すぐに医師に連絡してください。症状が生命を脅かすと思われる場合、または医療上の緊急事態が発生していると思われる場合は、911 または最寄りの緊急電話番号に電話してください。
重篤な副作用とその症状には次のようなものがあります。
これらの重大な副作用の詳細については、次の「副作用の詳細」セクションを参照してください。
副作用の詳細
この薬が引き起こす可能性のある特定の副作用について詳しく説明します。
血栓
レブロジル治療では、静脈または動脈に血栓が形成されるリスクがわずかにあります。この副作用はこの薬の臨床試験では一般的ではありませんでしたが、重篤になる可能性があります。
試験では、ベータサラセミアによって引き起こされる貧血を治療するためにレブロジルを服用した一部の人々で血栓が報告されました。報告されている血栓の種類は次のとおりです。
また、レブロジルの臨床試験中に虚血性脳卒中(脳内の血栓によって引き起こされる脳卒中)が発生したとの報告もあった。
臨床試験でこれらの副作用がどのくらいの頻度で発生したかを調べるには、Reblozyl の処方情報を参照してください。
血栓の症状には次のようなものがあります。
- 脚の痛みや腫れ
- 腕や脚が冷たい、または青白い
- 胸痛
- 呼吸困難
- 腹部の痛みまたは腫れ
- 体の片側の突然の衰弱またはしびれ
- 突然の頭痛または混乱
- 突然話すこと、見ること、歩くことが困難になる
過去に脾臓を摘出したことがある、または血栓があった場合、レブロジルによる血栓のリスクが高くなる可能性があります。喫煙したり特定の薬を服用したりすると、リスクが高くなる可能性があります。これらには、経口避妊薬やホルモン補充療法が含まれます。
レブロジルによる血栓のリスクが高いと医師が判断した場合、この副作用を防ぐために薬を処方することがあります。
Reblozyl 治療中に血栓の症状が現れた場合は、すぐに医師に相談してください。ただし、症状が生命を脅かすと思われる場合、または医療上の緊急事態が発生していると思われる場合は、911 または最寄りの緊急電話番号に電話してください。
血栓がある場合は、通常、治療が完了するまでレブロジルの投与を中止する必要があります。
高血圧
レブロジル治療中に高血圧が発生する可能性があります。この副作用は、この薬の臨床試験で一般的に報告されています。治験でこの副作用がどのくらいの頻度で発生したかを調べるには、Reblozyl の処方情報を参照してください。
高血圧は通常、症状を引き起こしません。ただし、心臓発作や脳卒中のリスクが高まる可能性があります。
Reblozyl を毎回投与する前に、医師が血圧を検査します。血圧が高すぎる場合、医師は血圧が管理されるまで治療を遅らせることがあります。医師は血圧を下げる薬を処方することもあります。すでに血圧の薬を服用している場合、医師は用量を増やすことがあります。
アレルギー反応ほとんどの薬と同様、レブロジルの投与後にアレルギー反応を起こす人もいます。
軽度のアレルギー反応の症状には次のようなものがあります。
- 皮膚の発疹
- かゆみ
- フラッシング
より重度のアレルギー反応が起こることはまれですが、可能性はあります。重度のアレルギー反応の症状には次のようなものがあります。
- 皮膚の下、通常はまぶた、唇、手、足の腫れ
- 舌、口、喉の腫れ
- 呼吸困難
レブロジルに対してアレルギー反応がある場合は、反応が重篤になる可能性があるため、すぐに医師に連絡してください。症状が生命を脅かすと思われる場合、または医療上の緊急事態が発生していると思われる場合は、911 または最寄りの緊急電話番号に電話してください。

Reblozyl は、特定の血液疾患を持つ成人の貧血(赤血球数の減少) を治療するために使用されます。具体的には、次のような成人に使用されます。
- ベータサラセミア、赤血球がヘモグロビンを正しく生成しない遺伝性疾患
- 特定の形態の骨髄異形成症候群 (MDS) 、骨髄と血液細胞に影響を与える癌のグループ
レブロジルは、これらの症状を持つ成人の赤血球数を増加させるのに役立ちます。
ベータサラセミアでは何が起こるのか
ベータサラセミアでは、遺伝した遺伝子の突然変異(変化)により、未熟な赤血球がヘモグロビンを正しく生成できなくなります。 (ヘモグロビンは、体の周りに酸素を移動させる赤血球内の分子です。)
その結果、体内で生成されるヘモグロビンが減少します。これは、未熟な赤血球の成熟を止める特定の信号を引き起こします。
未熟な赤血球が骨髄内に蓄積すると、健康な赤血球が発生して成熟するためのスペースが少なくなります。このため、ベータサラセミア患者の血液中の赤血球とヘモグロビンのレベルが低くなります。
骨髄異形成症候群で何が起こるか
MDS では、幹細胞に異常が発生し、成熟した血液細胞への成長が妨げられます。代わりに、それらは芽球と呼ばれる未熟な血球に成長します。
芽球は骨髄内に蓄積し、健康な血球が発生および成熟するためのスペースが少なくなります。このため、MDS の人は 1 つ以上の種類の血球、特に赤血球のレベルが低くなります。
レブロジルが行うこと
貧血治療におけるリブロジルの作用機序(仕組み)は、赤血球のレベルを高めることです。これは、より健康な赤血球が骨髄内で成熟するのを助けることによって行われます。これにより、貧血の治療に必要となる赤血球輸血の回数が減少します。
作業にはどのくらい時間がかかりますか?
Reblozyl は通常、最初の注射から約 1 週間後に効果を発揮し始めます。ただし、赤血球輸血の必要性が減るまでに数週間かかる場合があります。医師はヘモグロビンと赤血球のレベルをチェックすることで、治療がどの程度効果があるかを監視します。
Reblozyl の結果がいつ得られるかについて質問がある場合は、医師に相談してください。

レブロジルは皮下注射によって投与されます。医療専門家がオフィスまたは診療所で注射を行います。
上腕、太もも、腹部に注射を行う場合があります。
与えられるとき
レブロジルは通常 3 週間に 1 回投与されます。
レブロジル投与の予約を逃さないようにするには、携帯電話でアラームやタイマーを設定するか、リマインダー アプリをダウンロードしてみてください。

レブロジルはアルコールと相互作用することは知られていません。ただし、頭痛、めまい、下痢、吐き気などのレブロジルによる特定の副作用がある場合、アルコールを摂取すると症状が悪化する可能性があります。
アルコールを飲む場合は、レブロジル治療中にどれくらいの量を飲んでも安全かについて医師に相談してください。

Reblozyl は他のいくつかの薬剤と相互作用する可能性があります。
異なる相互作用は異なる効果を引き起こす可能性があります。たとえば、相互作用によっては、薬の効果が妨げられる場合があります。その他の相互作用により、副作用が増加したり、重症化する可能性があります。
レブロジルおよびその他の薬剤
Reblozylと相互作用する可能性のある薬のリストは次のとおりです。このリストには、Reblozyl と相互作用する可能性のあるすべての薬物が含まれているわけではありません。
リブロジル治療を開始する前に、医師または薬剤師に相談してください。あなたが服用しているすべての処方薬、市販薬、およびその他の薬について伝えてください。また、あなたが使用しているビタミン、ハーブ、サプリメントについても伝えてください。この情報を共有すると、潜在的な相互作用を回避できます。
あなたに影響を与える可能性のある薬物相互作用について質問がある場合は、医師または薬剤師に相談してください。
Reblozyl と相互作用する可能性のある薬物の種類は次のとおりです。
- 経口避妊薬: Reblozyl は血栓を引き起こすことがあります。レブロジルを含む経口避妊薬を服用すると、この副作用のリスクが高くなる可能性があります。例としては次のものが挙げられます。
- エチニルエストラジオール/デソゲストレル (Apri、Azurette、Kariva、Reclipsen)
- エチニルエストラジオール/ドロスピレノン (ロリーナ、オセラ、サイダ、ヤスミン、ヤズ、ザラ)
- エチニルエストラジオール/レボノルゲストレル (アビアン、レッシーナ、レボラ、ルテラ、ポーシャ、スロニクス)
- エチニルエストラジオール/ノルエチンドロン (バルジバ、ジュネル、ローストリン、ノートレル、オルトノヴム)
- エチニルエストラジオール/ノルゲスチメート (Ortho-Cyclen、Previfem、Sprintec)
- ホルモン補充療法 (HRT) : レブロジルは血栓を引き起こす場合があります。 Reblozyl と HRT を併用すると、この副作用のリスクが高くなる可能性があります。 HRT 薬の例には次のようなものがあります。
- エストラジオール/ドロスピレノン (アンジェリク)
- エストラジオール/レボノルゲストレル (クリマラ プロ)
- エストラジオール/ノルエチンドロン (アクティベラ、アマベルズ)
- エストラジオール/ノルゲスチメート (Prefest)
- エストラジオール/プロゲステロン ( Bijuva )
- エチニルエストラジオール/ノルエチンドロン (Jinteli)
- エストラジオールパッチ(クリマラ、ミニベル、ヴィベルドット)
- 経口エストロゲン(プレマリン)
- エストロゲン/メチルテストステロン (Covaryx)
- エストロゲン/バゼドキシフェン ( Duavee )
- エストロゲン/メドロキシプロゲステロン (Prempro、Premphase)
Reblozylとハーブとサプリメント
Reblozylと相互作用することが特に報告されているハーブやサプリメントはありません。ただし、Reblozyl の投与中にこれらの製品を使用する前に、医師または薬剤師に相談する必要があります。
レブロジルと食品
レブロジルと相互作用する食品は特に報告されていません。 Reblozyl と一緒に特定の食品を食べることについて質問がある場合は、医師に相談してください。

レブロジルは妊娠中に服用するのは安全ではありません。この薬は妊娠中の人を対象とした研究は行われていない。ただし、妊娠中に使用すると胎児に悪影響を与える可能性が考えられます。これは薬の作用方法と動物実験の結果に基づいています。
妊娠の可能性がある場合は、リブロジルを開始する前に妊娠検査を受ける必要があります。これは、薬を投与する前に医師があなたが妊娠していないことを確認できるようにするためです。
妊娠中または妊娠を計画している場合は、他の治療法について医師に相談してください。また、レブロジルの投与中に妊娠の可能性があると思われる場合は、すぐに医師に伝えてください。
リブロジルと生殖能力
レブロジルは妊娠能力に影響を与える可能性があります。動物実験では、この薬が女性の生殖能力を一時的に低下させることが判明した。これらの研究では、男性の生殖能力はこの薬の影響を受けませんでした。しかし、動物実験は人間に何が起こるかを必ずしも予測できるわけではありません。
レブロジルが生殖能力に及ぼす影響について心配な場合は、医師に相談してください。
注:性別とジェンダーはスペクトル上に存在します。この記事で使用する「男性」および「女性」という用語は、出生時に割り当てられた性別を指します。

レブロジルは妊娠中に服用するのは安全ではありません。性的に活動的で、あなたまたはあなたのパートナーが妊娠する可能性がある場合は、レブロジル治療中の避妊の必要性について医師に相談してください。
妊娠中のレブロジルの投与に関する詳細については、「レブロジルと妊娠」セクションを参照してください。
レブロジルを使用している女性の場合
女性は、レブロジルによる治療中および最後の投与後 3 か月間、効果的な避妊を行う必要があります。
レブロジルを使用している男性の場合
レブロジルの製造元は、この薬を使用する男性に対する避妊の推奨を行っていない。あなたがリブロジルを使用している男性で、妊娠する可能性のあるパートナーがいる場合は、治療中の避妊の必要性について医師に相談してください。
注:性別とジェンダーはスペクトル上に存在します。この記事で使用する「男性」および「女性」という用語は、出生時に割り当てられた性別を指します。

レブロジルによる治療中および最後の投与後 3 か月間は授乳しないでください。
レブロジルがヒトの母乳に移行するかどうかは不明です。しかし、母乳に混入した場合、母乳で育てられている子供に重篤な副作用を引き起こす可能性があります。
授乳中または授乳を予定している場合は、Reblozyl を使用する前に医師に相談してください。

ここでは、Reblozyl に関するよくある質問への回答を示します。
Reblozyl は私の症状を治しますか?
いいえ、Reblozyl では貧血の原因は治りません。
Reblozylは赤血球数を増やすのに役立ちます。ベータサラセミアや骨髄異形成症候群(MDS)によって引き起こされる貧血を軽減することができます。ただし、貧血を引き起こす病気を治すことはできません。また、ベータサラセミアまたはMDSによって引き起こされる貧血は、レブロジルの使用を中止すると再発する可能性があります。
Reblozyl が自分に効果があるかどうかはどうすればわかりますか?
Reblozyl が効果があるかどうかを示すことができることがいくつかあります。
- 貧血の症状が軽減し始めることに気づくかもしれません。たとえば、疲労感や息切れが軽くなることがあります。
- 赤血球輸血の必要性が減る可能性があります。
- 血液検査により、ヘモグロビンレベルの上昇が示される場合があります。
Reblozyl を最大 3 回投与しても必要な赤血球輸血の数が減らない場合は、この薬が効かない可能性があります。その場合は、Reblozylの使用を中止する必要があります。医師は貧血の管理に役立つ他の治療法を推奨します。
レブロジル治療中の血栓を防ぐにはどうすればよいですか?
Reblozyl 治療中の血栓を防ぐ方法がいくつかあります。これらには、禁煙、活動を続ける、適度な体重に達するか維持することが含まれます。
経口避妊薬やホルモン補充療法などの特定の薬剤も、血栓のリスクを高める可能性があります。これらの薬のいずれかを服用している場合は、考えられる代替薬について医師に相談してください。
Reblozyl による血栓のリスクを高める特定の要因がある場合、医師は抗凝血剤の服用について相談することがあります。これらは血栓の予防に役立つ薬です。
臨床試験では、レブロジルを服用したベータサラセミア患者数名で血栓が発生したことが報告されました。この副作用の詳細については、「 Reblozyl の副作用」セクションを参照してください。
リブロジル画像
レブロジル (luspatercept-aamt)・関連動画
参考文献一覧
- https://www.nccn.org/patients/guidelines/content/PDF/mds-patient.pdf
- https://www.reblozyl.com/mds/resources/financial-assistance
- https://www.accessdata.fda.gov/drugsatfda_docs/label/2024/761136s010lbl.pdf
- https://www.accessdata.fda.gov/scripts/medwatch/index.cfm
- https://www.accessdata.fda.gov/drugsatfda_docs/appletter/2020/761136Orig2s000ltr.pdf